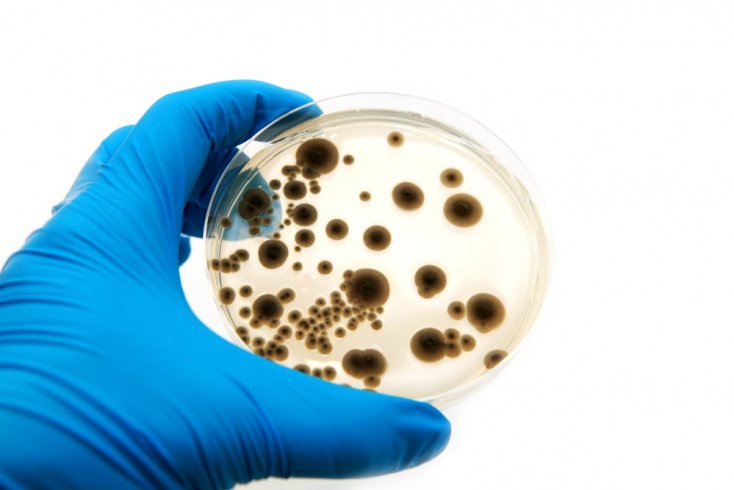

Вирусы бактерии грибки простейшие гельминты
ВНИМАНИЕ! Восстановить и сохранить здоровье можно! Читайте внимательнее сайт!
Заказать программу Gelmostop
Простейшие, бактерии, грибы, вирусы- это живые существа очень маленького размера.
Как и всякие живые организмы, они:
- питаются,
- дышат,
- выделяют продукты метаболизма
- и размножаются.
Они состоят всего лишь из одной клетки. Исключением являются вирусы, представляющие собой лишь часть клетки.
![]() | Микробы настолько малы, что их невозможно увидеть невооруженным глазом. Самые крупные из микробов, паразиты, приблизительно в 10 раз меньше толщины волоса, бактерии и дрожжи меньше его в 100 раз, а вирусы в 1000-10000 раз. |
Другими слови на площади в 1 миллиметр мы можем поместить соединенные вместе 10 волос, либо 1000 паразитов, 1000 бактерий или дрожжей и 100000 вирусных бактерий.
Их можно увидеть под микроскопом при гемосканировании…>>>
| — от 500 до 10 микрон | |||||||||||||||||||||
| — от 5 до 1 микрона | |||||||||||||||||||||
| — от 0,2 до 0,1 микрона | |||||||||||||||||||||
![]() | С изобретением микроскопа в XVII веке все то, что оставалось лишь гипотезой, было подтверждено. Первое наблюдение состоялось в 1680 году (голландец Антуан Ван Левенгук). Он увидел простейших, бактерии. Способ размножения микробов был открыт спустя 40 лет (итальянец Спалландзани). |
Однако доказательств того, что некоторые микробы являются источником различных заболеваний, было найдено лишь в 1865 году (француз Луи Пастер и немец Роберт Кох).
Начались систематические изучения микробов, взывающих инфекционные заболевания. В 1878 году был открыт стафилококк, в 1979 — стрептококк, в 1882 -бацилла туберкулеза, возбудитель холеры, позднее другие микробы.
Паразитарные заболевания
Простейшие
Болезни
Бактерии
Как и простейшие, бактерии отдают предпочтение определенным тканям и органам. Они там укореняются и вызывают повреждение этих тканей и органов.
Helicobacter pylori обитает в желудке и провоцирует гастрит и желудочные язвы
Эшерихия коли (Esherichia coli) — часто встречается в кишечнике, однако, покидая кишечную среду, становится заразной. Эта бацилла является причиной 80% инфекций мочевой системы.
Бацилла ботулизма опасна токсичными продуктами своей жизнедеятельности. Болезнь начинается в пищеварительном тракте, постепенно распространяясь на центральную нервную систему, вызывая паралич.
Стрептококк поражает почки и сердечные клапаны не из-за того, что находится в этих органах, а из-за токсинов, разносимых по организму кровью.
Бацилла Коха — причина туберкулеза
Стафилококки, стрептококки вызывают болезни кожи ( фурункулы, нарывы, гнойничковый лишай), горла (ангина, ринофарингит), ушей (отит), тонкой кишки (энтерит), легких (пневмония), мочевого пузыря (цистит), почек (пиелит), мозга (энцефалит) и т.д.
Дрожжи
Это микроскопические грибы, состоящие из одной клетки, близкой по своей клеточной структуре к бактерии.
Дрожжи в основном питаются сахаром и крахмалом, а также нуждаются в протеинах, витаминах и минералах.
Дрожжи лучше всего размножаются в кислой среде ( PH 4). Среди 350 видов дрожжей для человека опасны два два.
- Первый вызывает серьезную болезнь — грибковый менингит.
- Второй вид — кандида (candida albicans), обитатель кишечника, однако может развиваться и других частях тела (язвочки в складках губ, стомамикоз, эпидермофития стоп, опрелости, грибковые заболевания гениталий, молочница.
![]() | Грибки легко приживаются, а вот избавиться от них сложно, необходимо генеральное очищение организма, соблюдение диеты и здорового образ жизни. |
| Семейство грибов | Заболевания |
| Candida albicans |
|
| Cryticiccus neoformans |
|
Вирусы
Вирус, это генетический материал, окруженный защитным коконом.
Вирусы самые мелкие среди микробов. Размножение клетки полностью зависит от метаболизма клетки, в которой они обитают. Чтобы проникнуть в клетку, с которой вирус собирается вступить в контакт, он проделывает отверстие в мембране, пользуясь своими отростками. Его генетический материал поникает в клетку и закрепляется в ее генетическим материале. С этого момента генетическая информация вируса начинает вмешиваться в работу клетки.
Вирусы проникают не во все клетки а лишь в те, которые им предлагают подходящие условия для обитания — это клетки-мишени.
- для вируса свинки клетками мишени становятся слюнные железы,
- вируса гриппа — носа, глотки, гортани,
- вирус ВИЧ атакует клетки иммунной системы.
Вирусные заболевания:
- Лихорадка
- Энцефалит
- Менингит
- Инфекции дыхательных путей
- Герпес
- Ветряная оспа
- Опоясывающий лишай
- СПИД
- Грипп
- Корь
- Свинка
- Оспа
- Бешенство
При возникновении инфекции организм ускоряет все обменные процессы, что выражается в повышении температуры тела. Если повышение температуры и не убивает микробов, то делает условия их существования тяжелыми и невыносимыми. Поэтому:
- Не спешите при температуре принимать жаропонижающие средства, не мешайте работе организма!
- Не создавайте в организме подходящую среду для проживания и размножения микробов!
- Дважды в год проводите генеральную чистку организма (Gelmostop, Gelmostop-Mini)
- Принимайте ежедневно витамины, микро-макроэлементы (Элементы жизни, капсулы Ареда, фиточаи Ареда), минералы
- Ведите активный образ жизни
- Не злоупотребляйте алкоголем
- Не курите. Курение приводит к разрушению эритроцитов.
- Общайтесь с природой
В ослабленный организм проникают не только микробы извне, но и меняется среда в которой находятся человеческие сапрофиты. Нарушается баланс и возникает угроза здоровью. Например, кандида в небольшом количестве обитает в кишечнике и не доставляет человеку неудобств. Однако, как только внутренняя среда организма меняется в благоприятную для существования кандиды сторону, она начинает активно плодиться, что приводит к хроническому кандидозу.
Чрезмерное увеличение численности микробов превращает сапрофиты в опасные для человека!
В процессе возникновения заболеваний принимают участие две стороны: микроб и принимающая его среда, за которую отвечает человек . Микроб ничто, среда — все!
Берегите свою внутреннюю среду, соблюдая правила здорового образа жизни:
Подпишитесь на бесплатные рассылки и научитесь помогать себе самостоятельно!
Переходя от рассылки к рассылке, Вы поймете, как важны знания. Здоровье, это результат нашего выбора.

Интервью с Еленой Малышевой…>>

Here English-speaking people can seek for advice …>>
Cleansing of the organism
![]() |
Жители Сербии могут обратиться напрямую к представителю компании
Iz Srbije i okolnih zemalja mozete se javiti na srpskom jeziku predstavniku kompanije :
Многие тысячи лет люди жили в тесном контакте с бактериями, вирусами, простейшими, а также различными гельминтами и насекомыми-паразитами. В борьбе за выживание выигрывали сильнейшие, обладающие самыми совершенными механизмами защиты. У людей таким механизмом был иммунитет – врожденный и приобретенный в течение жизни. Контактируя с возбудителями, иммунная система активно обучалась защищаться от них, знакомясь с паразитами, она тренировалась образовывать антитела. Но времена изменились – в жизни людей появились горячая вода и антибактериальное мыло, система центральной канализации и средства бытовой химии, создающие стерильную чистоту. И ученые все чаще заявляют о том, что именно страсть к чистоте виновна в появлении аллергии, развитии астмы и многих других серьезных болезней. Но почему?
Так ли опасны бактерии и вирусы?
Инстинкты самосохранения во многих ситуациях подсказывают человеку модели поведения, позволяющие защитить свое здоровье. Поэтому люди подсознательно сторонятся грязных мест, дурно пахнущей пищи или плесени, порчи на продуктах. Это признак того, что там могут быть опасные бактерии, грибки или гельминты, которые могут вызвать опасные болезни. Но ученые считают, что микроскопические организмы, такие как бактерии, грибки и вирусы, которые живут в человеческом теле и слишком малы, чтобы их можно было увидеть невооруженным глазом, а также насекомые, гельминты и многие другие потенциальные возбудители болезней, имеют решающее значение для общего благополучия. Недавние исследования также показывают, что кишечный гельминт анкилостома может не только вредить, но и помогать, например, бороться с астмой и другими хроническими заболеваниями.

С появлением современной системы туалетов и канализации в начале 1900-х годов и последующими достижениями в разработке антибактериального мыла и других сильных чистящих средств условия жизни во многих странах стали намного более гигиеничными, чем у предыдущих поколений. И это стало проблемой человеческого иммунитета. Многие эксперты говорят, что аллергия и многие аутоиммунные болезни, которые раньше встречались как единичные случаи, сегодня приобрели глобальные масштабы именно в силу маниакального стремления к чистоте. Человеческий страх перед бактериями и эпидемиями инфекций подтолкнул людей к стремлению сохранить все в безопасности и стерильности. Эта крайность причиняет человеку больший вред, чем помогает. Иммунная система без адекватной тренировки и вирусных, микробных раздражителей начинает бунтовать – отсюда аллергия и аутоагрессия. Если ранее она была занята отражением атак бесчисленных бактерий и вирусов, формируя к ним иммунитет, синтезируя антитела и защитные молекулы, то сегодня инфекционных раздражителей в разы меньше, а иных (пища, химия, косметика и т. д.) – больше. Поэтому возникают реакции на вполне безобидные вещества – пыльцу, рыбу, яйца, косметику – и так провоцируется аллергия.
Влияние микробов на формирование иммунитета
Оставьте свой email, чтобы всегда получать важную информацию и сервисы для сохранения вашего здоровья
Гельминты: опасные или полезные?
Анкилостома Нового Света (Necator americanus) – это кишечный гельминт, встречающийся в тропическом климате, например, Центральной Америки и Вест-Индии. Его не стоит путать с анкилостомой Старого Света (Ancylostoma duodenale) – это паразит родом из некоторых частей Европы, Индии и других регионов. Гельминты длинные и тонкие, они имеют крючья, которые используют, чтобы зарыться в стенку кишечника человека, где они обитают и питаются кровью. И их наличие может однажды помочь бороться с астмой. Исследование 2016 года в Science Translational Medicine обнаружило, что паразит анкилостома вырабатывает белок, который помогает ослабить симптомы астмы у мышей. Отдельное исследование, проведенное в 2016 году в журнале Science, показало, что кормление мышей кишечными гельминтами активизирует слизистые клетки в их кишечнике, что помогает им бороться с болезнью Крона.
Это исследование кажется многообещающим, но для того, чтобы определить, могут ли кишечные гельминты, которые нетипичны для людей в развитых странах, помочь в борьбе с болезнями человека, необходимы большие клинические исследования. Если они могут победить аллергию или приступы астмы, исследователи могли бы извлечь из червей материал для борьбы с болезнями и предоставить его людям в таблетках или в жидкой форме.
Боязнь бактерий и паразитов
Многие люди очень боятся бактерий, вирусов и паразитов, считая, что они могут причинить им серьезный вред. Но стерильность вредит здоровью не меньше, чем какой либо паразит или вирус. Многие ученые верят в гигиеническую гипотезу, согласно которой людям, проживающим в районах с высокими санитарными условиями, не хватает нормального эволюционного воздействия микробов, пыльцы, паразитов и других микроскопических веществ в окружающей среде. Отсутствие этого воздействия негативно влияет на развитие их иммунной системы. Конечно, ученые совершенно не против соблюдения элементарных правил гигиены. Но многие люди перебарщивают с использованием антибактериального мыла и средств для уничтожения микробов. Эти вещества беспорядочно убивают все живое, включая полезные бактерии, которые помогают поддерживать сильный и разнообразный микробиом кишечника. У каждого есть своя микрофлора – коллекция из примерно 100 триллионов бактериальных клеток, прежде всего в желудочно-кишечном тракте. Чем разнообразнее собственный микробиом, тем здоровее человек. Он укрепляет иммунную систему.
Исследование, опубликованное в 2015 году в Occupational & Environmental Medicine, раскрывает последствия применения отбеливателя – эффективного средства для уничтожения микробов. Было показано, что заболеваемость инфекциями, такими как грипп, тонзиллит, синусит, бронхит и пневмония, была более распространенной в домах, где использовался отбеливатель. В исследовании, опубликованном в 2015 году в журнале Science Translational Medicine, ученые изучили образцы стула 319 детей и обнаружили, что у 22 из тех, кто подвергался наибольшему риску астмы, было гораздо меньшее количество четырех конкретных видов полезных бактерий, чем у детей, которые не подвергались риску астмы. Это говорит о том, что присутствие этих четырех микробов в раннем возрасте может быть связано с защитой детей от астмы.
Человек на протяжении жизни, загруженный своими проблемами, работой, домашними делами, все время сталкивается с параллельными мирами, о существовании которых даже не подозревает. А ведь жители этих миров – постоянные спутники человека, и сопутствуют ему не только во внешней среде, но и во внутренней. Вирусы, бактерии и простейшие – кто они, эти загадочные жители нашей планеты? В чем отличие между ними, какая от них польза и вред?
Ответы на эти вопросы стоит узнать для того, чтобы понимать, кто из простейших, бактерий или вирусов человеку друг, а кто враг, как ограничить общение с врагами или помочь избавиться от их негативного воздействия, как определять степень загрязнения простейшими, вирусами или бактериями той или иной среды. Также нужно научиться понимать разницу между заболеваниями, вызванными разными возбудителями, научиться их правильно лечить. Для этого необходимо рассмотреть каждый вид микробов в отдельности.
Понятие вирусов, их классификация
Вирусы – это самые маленькие и неклеточные формы жизни, рассмотреть которые возможно только с помощью электронного микроскопа. Они характеризуются своей избирательностью, то есть определенный вирус может размножаться только в определенной среде (внутреннем органе человека).
- палочковидными;
- сферическими;
- нитевидными;
- в виде сперматозоида.
Вирус не имеет тела, поэтому ему для размножения нужна определенная клетка. Будучи намного меньше, он, попадая сквозь клеточную оболочку внутрь, завладевает ее телом. Вследствие этого клетка перестает выполнять свои функции и начинает служить вирусу.
Антитела к вирусной инфекции не могут выработаться быстро, потому что система иммунитета не сразу может разглядеть в своей родной клетке врага и потенциальную опасность.
Каждый вирус способен поражать только определенный вид клеток:
- гепатит размножается только в печени;
- вирус гриппа поражает слизистую оболочку трахеи или бронхов;
- энцефалит возникает в головном мозге;
- эпидемический паротит выбирает слюнные железы.
Наиболее страшным является вирус иммунодефицита человека (ВИЧ). Он поражает иммунные клетки, вследствие чего перестает вырабатываться иммунитет против любых других вредоносных микроорганизмов. Инфицированный ВИЧ может умереть от любой излечимой у обычного человека болезни (пневмония, туберкулез). Больные в обязательном порядке получают антиретровирусную терапию, которая сдерживает размножение вируса и способствует уменьшению его количества. Эффективного лекарства от вируса иммунодефицита до сих пор не существует, хотя ведется его активная разработка.
Вирус гепатита C поражает печень. Болезнь, вызванная вирусом, может протекать в бессимптомной форме (в течение нескольких лет), постепенно перерастать в хроническую неизлечимую форму, которая приводит к циррозу или раку печени. Лечение гепатита С дорогостоящее и длительное, поэтому для широких масс населения остается недоступным.
Источники передачи вирусов:
- через потоки воздуха посредством попавших в него частичек слюны, жидкости из носовых путей;
- вирусы содержатся в любых физиологических жидкостях и могут передаваться от них (кровь, грудное молоко, сперма);
- путем попадания в кровь (переливание зараженной крови, укол или порез зараженным предметом, даже через поцелуи, если во рту или на губах есть открытые ранки);
- половым путем;
- во время родов от матери к ребенку.
Из-за способности проникать в клетку и становиться незаметным, вирус невозможно убить, не уничтожив клетку. Поэтому препаратов против вирусов с доказанной эффективностью очень мало. Разработаны они только для определенных видов вирусов, имеют множество противопоказаний.
Антибиотиками остановить вирусную инфекцию невозможно, потому что антибиотики не могут уничтожить клетку, а соответственно, и сидящий в ней вирус.
Единственное правильное решение при лечении от вируса – дать организму самому справиться с болезнью, выработать иммунитет. Для этого необходимо создать определенные условия:
- употреблять большое количество жидкости;
- при поражении слизистых оболочек (грипп, ОРВИ) увлажнять их солевыми растворами;
- уменьшить нагрузку на систему пищеварения с помощью диеты;
- применять препараты, снимающие симптомы (жаропонижающие, антигистаминные, болеутоляющие).
Профилактика инфекций, вызываемых вирусами, заключается в следующих действиях:
- своевременная вакцинация от наиболее тяжелых и опасных форм заболеваний (гепатит В, грипп, краснуха, корь, клещевой энцефалит, полиомиелит);
- ограничение контактов с больными;
- разборчивость в сексуальных отношениях и обязательное предохранение с помощью презерватива;
- излечение от наркозависимости, использование инъекционными наркоманами одноразовых стерильных шприцев;
- использование стерильных инструментов при заборах крови для анализов, инъекций, операций.
Что такое бактерии, какими они бывают
Бактерии – это одноклеточные организмы, которые несут в себе ДНК или РНК, находящееся в ядерном веществе (нуклеоиде), окруженном оболочкой. То есть это вполне самостоятельный организм, способный размножаться.
По внешнему признаку бактерии разделяют следующим образом:
- палочковидные (бациллы);
- спиральные (спириллы);
- сферические (кокки).
Бактерии – это древнейшая и самая первая форма жизни на Земле. Раскопки каменных образований, появившихся вследствие их жизнедеятельности, показали, что бактерии населяли планету еще 3,5 млрд. лет назад.
Эти микробы могут жить практически в любой среде: в почве, воде, земле. Бактерии были найдены даже в Мертвом море, в кислотных источниках с температурой воды выше 90°С, на высоте до 8 км от земли.
Эти формы жизни населяют организм животных и человека. Наибольшее количество бактерий находится в толстом и тонком кишечнике. Вреда они не причиняют, наоборот, полезны.
- Молочнокислые лактобактерии (Lactobacillus), бифидобактерии (Bifidobacterium) перерабатывая лактозу, образовывают молочную кислоту, которая способствует пищеварению, выделению кишечного сока, препятствует размножению патогенных микроорганизмов. Также они вырабатывают ферменты, помогающие переваривать пищу.
- Энтерококки играют свою роль в процессе переваривания пищи.
- Бактероиды (Bacteroides) – способны расщеплять желчь.
- Кишечная палочка (Escherichia coli) продуцирует витамины группы B и K, вырабатывает вещества, положительно влияющие на перистальтику.
Кроме полезных, существуют нейтральные бактерии. Они находятся на стороне тех бактерий, численность которых больше, и выполняют их функции. Патогенные же бактерии являются источниками инфекционных заболеваний.
- Инфекционный тонзиллит (ангина), ревматические заболевания суставов, сердца, легких, оболочек головного мозга, скарлатина – все это вызывает бактерия стрептококк (Streptococcus).
- Смертельная форма туберкулеза, инфекции лимфоузлов — микобактерии (Mycobacterium).
- Брюшной тиф, заражение крови и лимфоидной системы провоцирует бактерия сальмонелла (Salmonella).
- Заражение крови, печени, гнойные процессы открытых ран, высыпаний — работа бактерии стафилококк (Staphylococcus).
- Ботулизм (сильнейшее пищевое отравление) вызывает бактерия Clostridium botulinum, обитающая в почве.
- Менингит вызван бактерией под названием гемофильная палочка (Haemophilus influenzae).
Причем опасными являются токсины, которые вырабатывают бактерии в процессе своей жизнедеятельности. Токсины отравляют и загрязняют кровь. Именно токсины бактерий являются виновниками плохого самочувствия, лихорадки и болей.
Не все опасные микробы, находящиеся внутри человека, способны вызывать болезни и инфекционные процессы. Они просто могут мирно и спокойно жить не размножаясь. Такие бактерии лечить не следует, если человек не заразен (например, стафилококк спокойно живет на коже, а стрептококк – в горле и на миндалинах). Пока человек здоров, не ослаблен различными инфекциями, в том числе вирусными, бактерии не размножаются слишком интенсивно. Но в любой момент они могут начать свою патогенную активность – вот тогда и понадобится лечение.
Все бактерии легко убиваются антибиотиками. Некоторые из них – более сильными по составу лекарствами, некоторые – обычным пенициллином. Антибиотик должен подбирать квалифицированный врач.
Главное правило приема антибиотиков – это длительность. Ни в коем случае нельзя прекращать курс, когда наступило облегчение или ушли симптомы. Для того, чтобы убить все микроорганизмы, следует принимать лекарства до конца назначенного лечения, иначе оставшиеся в живых бактерии начнут свою деятельность с новой силой, выработав защиту от данного вида лекарства.
Профилактика заболеваний, вызванных бактериями, включает следующие действия:
- ограничение общения с источниками заражений — заболевшими людьми, так как пути передачи инфекции в основном представлены контактным и воздушно-капельным;
- соблюдение правил личной гигиены, мытье рук после посещения туалета;
- удаление загрязнений с поверхности, контактирующей с пищей;
- своевременное лечение для предотвращения осложнений;
- неупотребление воды и продуктов с загрязнениями в пищу.
Простейшие: кто они?
Простейшие (Protozoa) – одноклеточные миниатюрные животные. У простейших есть тело, у некоторых – внутренний или наружный скелет (раковина, панцирь), собственный обмен веществ.
Размножение простейших происходит половым или бесполым путем (делением). Большинство из простейших живут в почве, пресной воде – чистой или с загрязнениями. Но многие являются паразитами и обитают в человеке.
Простейшие разделяются на классы:
- Саркодовые (Rhizopoda) простейшие обитают в водоемах. Большинство загрязняют воду и паразитируют в человеке.
- Жгутиковые простейшие (Mastigophora) заселяют водоемы, человеческий и животный организм.
- Простейшие споровики (Sporozoa) являются паразитами.
- Книдоспоридии (Cnidosporidia) паразитируют внутри рыб, насекомых, пауков.
- Простейшие инфузории (Infusoria) живут повсюду в окружающей среде.
В основном простейшие являются паразитами, вызывая те или иные заболевания у человека.
- Лямблии вызывают лямблиоз. Данные простейшие размножаются, выделяя цисты-яйца и приводя к загрязнению земли, песка. Также источниками заражения простейшими служит вода с загрязнениями (хлор не способен убить цисты лямблий). Большинство людей являются носителями данных простейших, не подозревая об этом. Между учеными ведутся споры о том, следует ли лечить лямблии. Некоторые склоняются к тому, что лучше оставить их в покое, если носительство проходит бессимптомно и не доставляет неприятных ощущений.
- Простейшее токсоплазма (Toxoplasma gondii) является возбудителем токсоплазмоза – опасного заболевания во время беременности, способного привести к патологиям плода или к его смерти, так как данные простейшие могут проникать сквозь плаценту. В остальных случаях болезнь переносится бессимптомно, к простейшему вырабатывается пожизненный иммунитет. Основным источником заражения являются кошки. Только в кишечнике этого животного простейшее токсоплазма способна размножаться. С кошачьими испражнениями выделяется до 2 млрд. цист простейшего в окружающую среду. Также заразиться этим простейшим можно, отведав сырого мяса, немытых фруктов, покопавшись в песке или земле с загрязнением цистами.
- Простейшее Трихомонада (Trichomonas vaginalis) вызывает заболевание, передающееся только половым путем, – трихомониаз. Простейшие семейства, обитая во влагалище, питаются бактериями, эритроцитами, эпителиальными клетками. Заболеть могут как мужчины, так и женщины, но у женщин вероятность подхватить простейшее от зараженного партнера при незащищенном половом акте более высока.
Хламидии – отдельный род
Отдельно стоит описать хламидии, которые не относятся ни к простейшим, ни к вирусам или бактериям. По внешности они схожи с бактериями, но имеют очень маленький размер и способны проникать в клетку в точности, как вирусы. Внедряясь в нее, хламидии размножаются, производя крупные незаразные образования. Постепенно образования уменьшаются, выходят из клеток, разрушая их, и проникают в клетки здоровые. Хламидии способны вызывать такие заболевания, как урогенитальный хламидиоз, орнитоз (воспаление легких), болезнь кошачьих царапин.
Переносчиками и источниками являются домашние птицы, кошки. Передается инфекция воздушным и пылевым путем, от немытых рук, пищи с загрязнениями.
Для лечения заболеваний, вызванных хламидиями, применяются антибиотики. Иммунитет у человека не вырабатывается, поэтому заболевать можно бесконечное количество раз.
Только ли в лесу растут грибы?
Грибы-паразиты, или дрожжи, обитают на теле человека, а также на слизистых оболочках и во внутренних органах, вызывая грибковые заболевания. Размножаются они в кислотных средах, питаясь крахмалом и сахаром. Грибки способны выдерживать высокие и низкие температуры, им не страшна заморозка, уничтожить их практически невозможно.
Грибы получают энергию в процессе брожения. Эти гетеротрофы переваривают пищу с помощью выделения в окружающую среду специальных ферментов. Некоторые грибы поражают живой организм, вызывая его смерть, после чего живут на мертвых останках, питаясь их средой.
Мир грибов окружает людей повсюду, размножаясь и выделяя споры, вызывающие болезни.
Для человека наиболее опасны грибы:
- Кандида (Candida), являясь условно-патогенным обитателем слизистых оболочек, поверхности языка, влагалища, носоглотки, прямой кишки способны вызывать кандидоз. Обитая мирно в организме человека, дрожжевые грибы начинают размножаться при ослабевании его защитных свойств.
- Грибы вида Cryticiccus neoformans вызывают менингит – воспаление коры головного мозга.
- Дрожжевой гриб Coccidioides immitis — возбудитель кокцидиоидоза. Болезни дыхательных путей, сопровождающиеся кашлем, затрудненным дыханием, болью в груди. Заражение происходит после вдыхания пыли с поверхности, содержащей споры.
- Cryptococcus neoformans – вид дрожжевого грибка, локализующего в мозге, его оболочках, возбуждает болезнь под названием криптококкоз. Отсутствие лечения может привести к параличу, летальному исходу.
- Sporotrichum schenckii – грибок, поражающий кожу стоп.
- Pityrosporum orbiculare является возбудителем дерматомикозов, причиной разноцветного отрубевидного лишая.
Грибы – это причина перхоти, дерматитов, псориазов, лишаев. Лечение заключается в применении противогрибковых препаратов, мазей.
Другие паразитарные формы жизни – гельминты
Гельминты – эти паразиты-черви, размножающиеся половым путем в кишечнике и других внутренних органах человека и животных, откладывая яйца.
Выделяют следующие классы:
- круглые раздельнополые черви;
- плоские (ленточные) черви;
- сосальщики, присасывающиеся к жертве с помощью присосок.
Гельминты в человеческом организме вызывают аскаридоз, энтеробиоз, трихинеллез, стронгилоидоз и другие заболевания в зависимости от вида паразита. Яйца некоторых видов гельминтов способны сохранять активность в окружающей среде длительное время, попадая в человеческий организм с пищей, водой, имеющими загрязнения.
Все существующие патогенные микроорганизмы могут мирно сосуществовать, не принося человеку вреда. Главная защита от любых паразитов – это своевременная профилактика, соблюдение элементарных принципов гигиены, борьба с бытовыми загрязнениями, тепловая обработка пищи. Следует помнить, что здоровый крепкий иммунитет в сочетании с правильно подобранными лекарственными препаратами способен побороть большинство опасных заболеваний.
Работаю врачом ветеринарной медицины. Увлекаюсь бальными танцами, спортом и йогой. В приоритет ставлю личностное развитие и освоение духовных практик. Любимые темы: ветеринария, биология, строительство, ремонт, путешествия. Табу: юриспруденция, политика, IT-технологии и компьютерные игры.
Читайте также:
- Гепатит передается через ножницы
- Тест иммунохроматографический для выявления ротавируса в кале рэд 1
- Сказка про грипп для детей
- Китайцы завезли в россию вирус
- Прыщи на лице вирус папилломы человека






